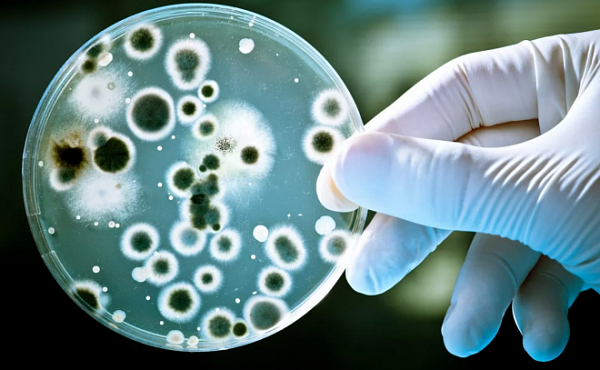

Биологи из Японии и США смогли оживить древних микробов

Всё это время микробы «спали» вечным сном на морском дне в осадочных породах, состоящих из сора и частиц, которые переносят морские течения. Извлечь их удалось путём бурения отверстий в породе — их учёные пробурили, чтобы сделать заборы образцов.
Сначала планировалось поискать в этой толще микробы, способные выживать без кислорода и питательных веществ. На роль таких микробов внезапно подошли их древние предки, которые не только оживились после помещения их в правильную среду и стали есть, но и через некоторое время принялись размножаться, демонстрируя потрясающую активность и живучесть: в питательной среде оправилось более 99 процентов добытых учёными микробов.
Ничего необычного в их поведении замечено не было: микробы как микробы, живут такой же размеренной жизнью, что и миллионы лет назад. Учёные пояснили, что сама жизнь этих микробов была очень неспешна под огромной толщей воды, поэтому исследование таких организмов может помочь последить за их изменениями и эволюцией.
Наука
Вячеслав Ларионов


 Этот ультрамилый робот умеет довольно урчать и вилять хвостом
Этот ультрамилый робот умеет довольно урчать и вилять хвостом В Израиле научились получать этанол из отходов
В Израиле научились получать этанол из отходов








